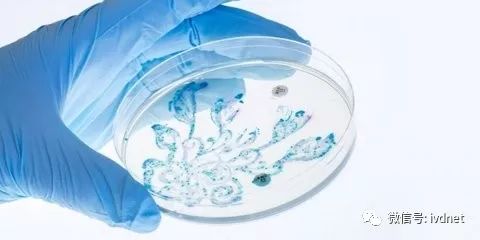
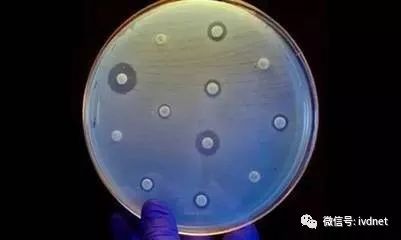

编者按:
微生物检测是IVD的一个细分领域,在众多细分领域中仅次于POCT,我国的微生物检测行业预计2022年将达到30.7亿元,年复合增长率为17.52% ,微生物检测逐步成为IVD市场的宠儿。
今天小编为大家带来微生物已有相关专家共识检测市场的信息盘点。
我国医疗机构常规临床微生物检测项目有8大类,152项,主要包括:真菌、放线菌、螺旋体、细菌、立克次氏体、衣原体、病毒和支原体。其中细菌检测81项,占比为52.5%。
微生物技术分类
目前,微生物实验室使用的检测产品大部分以传统方法为基础。
1.直接镜检:
染色涂片镜检。
2.常规检验
(1)分离培养:微生物培养。
(2)细菌鉴定:形态观察、生化反应、血清学试验。
(3)药敏试验:抑菌试验、杀菌试验、脸和药敏试验、抗生素灭活酶。
3.快速诊断:
(1)特异性抗原检测:
免疫荧光技术、胶乳凝集试验、酶免技术、对流免疫电泳、化学发光免疫。
(2)核酸检测:
核酸探针杂交和PCR技术。
(3)质谱检测:
MALDI-TOF MS技术,LC-MS技术。
《细菌与真菌涂片镜检和培养结果报告规范专家共识》
临床微生物形态学检验对感染性疾病的早期诊断具有重要临床意义,可以在第一时间通过细胞学特点、微生物形态学特征等对可能感染的病原体进行诊断,实现早期诊断、早期治疗的目的,对提高患者的生存率有重要意义。
直接镜检的临床应用方向
多样本检测及分析,为临床提供病原学依据。
将微生物形态学所蕴含的诊断和治疗信息最大程度地诠释给临床,加强微生物实验室与临床的沟通,更好地为感染性疾病的早期诊断和治疗提供病原学依据。
常见染色剂厂家(节选)
1.革兰染色液 冀食药监械(准)字2009第1400003号 河北微拉生物科技有限公司
2.革兰染色液 豫食药监械(准)字2012第1400034号 郑州博赛生物技术股份有限公司
3.革兰染色液 粤食药监械(准)字2010第1400082号 深圳市怡百世生物科技有限公司
4.革兰染色液 冀食药监械(准)字2013第1400014号 众爱生河北生物科技有限公司
5.革兰染色液 皖食药监械(准)字2011第1400165号) 合肥天达诊断试剂有限公司
6.革兰染色液 浙食药监械(准)字2009第1400015号 杭州威晟生物科技有限公司
7.革兰染色液 苏食药监械(准)字2014第1400342号 苏州微利特生物科技有限公司
8.Atkins革兰染色液 渝食药监械(准)字2011第1400090号 重庆庞通医疗器械有限公司
9.抗酸杆菌染色液试剂(抗酸染色法) 川食药监械(准)字2010第1400057号(更) 四川新健康成生物股份有限公司
10.抗酸杆菌染色液试剂(抗酸染色法) 川食药监械(准)字2010第1400057号 四川省新成生物科技有限责任公司
11.抗酸杆菌染色液试剂盒 苏宁食药监械(准)字2012第1400038号 南京荣春生物科技有限公司
《常见细菌药物敏感性试验报告规范中国专家共识》
药物敏感性试验可以检测细菌对于抗细菌药物的敏感性,为临床用药、新药研究、监测耐药变迁、发现耐药机制等提供客观证据 。
药敏试验的临床应用方向
1)多样本不可药敏试验的注意事项
(1)脑脊髓液:
正常和疾病状态不能穿透血脑屏障的药物,常规不应报告。报告审核时,对于分离自脑脊髓液的菌,下列药物不能报告:仅有口服剂型的抗菌药物、一、二代头孢菌素(除外静脉用头孢呋辛)、头霉素类、克林霉素、大环内酯类、四环素类和喹诺酮类。
(2)尿液:
有些药物如呋喃妥因,仅限于测试和报告尿分离株,其他标本的分离株,不应报告此药;尿道标本常规不应报告氯霉素。
(3)呼吸道分泌物:
呼吸道标本分离株不应测试和报告达托霉素的敏感性。
2)细菌耐药试验预设药的注意事项
1.苯唑西林:预报葡萄球菌属对β内酰胺类药物(除头孢洛林外)的敏感性。
2.苯唑西林(纸片法):预报肺炎链球菌对青霉素的敏感性。
3.四环素敏感:预测多西环素、米诺环素敏感。
4.肠球菌对青霉素敏感:预测肠球菌属对氨苄西林、阿莫西林、哌拉西林、氨苄西林/舒巴坦等敏感;但氨苄西林敏感,不能预测青霉素为敏感。
5.头孢唑林:其结果可以预报非复杂性的泌尿系统感染的大肠埃希菌、肺炎克雷伯菌和奇异变形杆菌对口服头孢拉定、头孢地尼、头孢克罗、头孢丙烯、头孢泊肟、头孢呋辛的敏感性。
6.红霉素敏感:可以预测克拉霉素、阿奇霉素、地红霉素敏感。
7.万古霉素敏感:预报对**拉宁敏感。
在药敏试验中,由某一药物的药敏结果可以“预报”或“指示”其他药物敏感或耐药的药物,该药物即预报药或指示药,为药物选择提供病原学证据。
常见药敏试验厂家
1.GC琼脂药敏试验培养基 渝械注准20152400124 重庆庞通医疗器械有限公司
2.M-H药敏试验血琼脂平板(MHBA) 渝食药监械(准)字2014第2400122号 重庆庞通医疗器械有限公司
3.支原体培养、鉴定、计数及药敏试验试剂盒(比色法) 国食药监械(进)字2012第2403183号bioMerieux, sa
4.真菌药敏试验琼脂平板(MHGMB) 渝食药监械(准)字2011第2400094号 重庆庞通医疗器械有限公司
5.药敏试验培养基 浙械注准20162400461 温州市康泰生物科技有限公司
6.厌氧菌生化药敏试验卡 湘食药监械(准)字2014第2400105号 湖南长沙天地人生物科技有限公司
7.奈瑟菌/嗜血杆菌生化药敏试验卡 湘食药监械(准)字2010第2400163号 湖南长沙天地人生物科技有限公司
8.弧菌科细菌生化药敏试验卡 湘食药监械(准)字2010第2400164号 湖南长沙天地人生物科技有限公司
9.球菌科细菌生化药敏试验卡 湘食药监械(准)字2010第2400159号 湖南长沙天地人生物科技有限公司
10.肠杆菌科细菌生化药敏试验卡 湘食药监械(准)字2010第2400158号 湖南长沙天地人生物科技有限公司
11.酵母样真菌生化药敏试验卡 湘食药监械(准)字2010第2400162号 湖南长沙天地人生物科技有限公司
12.链球菌科细菌生化药敏试验卡 湘食药监械(准)字2010第2400161号 湖南长沙天地人生物科技有限公司
《中国临床微生物质谱应用专家共识》
MALDI-TOF MS技术为临床微生物检验领域带来了革命。《中国临床微生物质谱应用专家共识》的制定,将进一步规范MALDI-TOF MS技术在临床微生物实验室的应用,提高临床微生物诊断能力,缩短TAT,最终实现临床受益。
飞行时间质谱仪的临床应用方向
1)直接样本快速鉴定
(1)尿液样本
应用MALDI-TOF MS仪只需简单前处理可直接检测,可在2h内完成菌种鉴定,比尿培养加MALDI-TOF MS菌落鉴定提前平均20h,比常规的尿培养鉴定提前平均34-46h。
(2)血培养阳性瓶取样
MALDI-TOF MS仪能够对葡萄球菌属、肠球菌属、肠杆菌科、非发酵菌群等临床常见细菌以及念珠菌属酵母菌属等真菌进行可信鉴定,是临床微生物实验室病原菌诊断的有力工具。
2)经过培养之后,细菌耐药试验
MALDI-TOF MS细菌指纹图谱鉴定细菌,建立区分金黄色葡萄球菌甲氧苯青霉素耐药株和敏感株的分析方法,结果显示应用MALDI-TOF MS检测细菌耐药性时,对葡萄球菌检测结果较好。
MALDI-TOF MS飞行时间质谱仪直接检测尿液样本中的细菌是对基于培养的传统方法的革命性创举。
常见质谱仪厂家
1.AB SCIEX Triple Quad™ 4500MD,液相色谱串联质谱检测系统LC/MS/MS System,国械注进20172401554
2.Microflex LT/SH,全自动快速生物质谱检测系统,国食药监械(进)字2014第2402363号
3.VITEK MS,全自动微生物质谱检测系统,国械注进20162402385
4.ACQUITY I-S,超高效液相色谱串联质谱系统(ACQUITY UPLC I-Class IVD / Xevo TQ-S IVD System),国械注进20152400515
5.ACQUITY I-X,超高效液相色谱串联质谱系统(ACQUITY UPLC I-Class IVD / Xevo TQ-D IVD System),国械注进20152401820
6.ACQUITY,超高效液相色谱串联质谱系统(ACQUITY UPLC/MS/MS System),国食药监械(进)字2014第2401651号
7.API 3200MDTM,LC/MS/MS System,国食药监械(进)字2014第2404175
8.Clin-ToF-Ι,飞行时间质谱系统(Clin-ToF-Ι),京食药监械(准)字2014第2400606号,北京毅新博创生物科技有限公司

/3
/3 





 浙公网安备33010802005999号
浙公网安备33010802005999号


